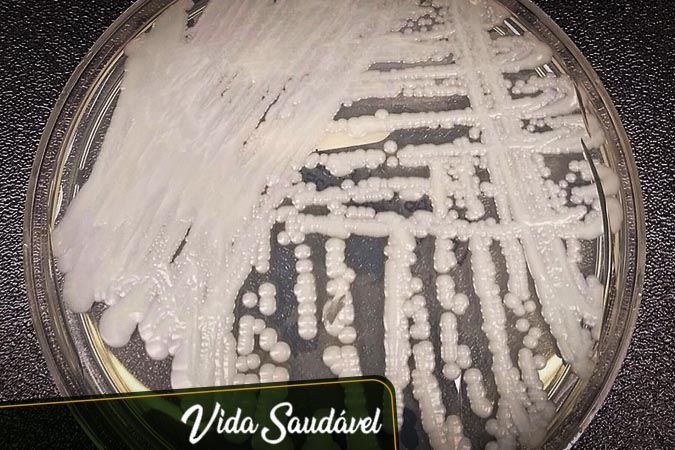

Enquanto ainda lutamos contra a pandemia do Coronavírus, a Agência Nacional de Vigilância Sanitária (Anvisa) confirmou surtos de infecção pelo fungo da espécie Candida auris, conhecido como superfungo. O primeiro surto da doença ocorreu em dezembro de 2020, somando quinze casos e dois óbitos na cidade de Salvador. Em 2021, houve o segundo surto, com um caso de infecção confirmado na mesma região.
Em janeiro deste ano, a Anvisa foi notificada sobre o terceiro surto com dois casos na cidade de Recife, e outros dois em Pernambuco. Por isso, a Agência emitiu um alerta de ameaça a saúde pública, considerando a multirresistência do superfungo à medicamentos e desinfetantes, gravidade de infecção, resistência e consequente alta capacidade de causar surtos.
Os fungos do tipo Candida estão presentes na nossa flora intestinal, pele, boca e genitais, causando problemas quando o organismo se encontra em desequilíbrio, com baixa imunidade ou assim que exposto a infecções invasivas. Não por acaso, os casos de infecções pelo superfungo se intensificaram durante a pandemia, ocasião em que o sistema imunológico é enfraquecido, e as internações prolongadas aumentam as chances de contaminação do Candida auris.
Principais sintomas da infecção
Além da multirresistência do fungo aos fármacos – principal causa para a facilidade de sua dispersão – segundo a Anvisa, o organismo pode ser fatal, apresentando taxa de mortalidade entre 30% e 60%, ou seja, no mínimo um terço das pessoas infectadas não resistem à doença. Conheça os principais sintomas da infecção:
• Aumento da frequência cardíaca;
• Fadiga;
• Febre alta;
• Tontura;
• Vômitos.
Segundo estudo nacional publicado no periódico científico Journal of Fungi, um dos principais fatores de risco para a infecção pode ser a contaminação por Covid-19. Ao analisar os relatos de casos confirmados na Bahia, foi levantada a hipótese de que todos os pacientes já estavam infectados pela doença em questão, e devido a exposição à antibióticos e procedimentos médicos invasivos contra ela, foram desenvolvidas as superinfecções pelo fungo no ambiente hospitalar.
Dessa forma, a principal maneira de evitar a infecção e possível morte causada pela espécie Candia, é através da imunização contra o Coronavírus. Ao mesmo tempo, pesquisadores analisaram o diabetes, falência renal, uso de diversos antibióticos, cateter venoso e excesso de corticoides como outros fatores de risco para o surgimento de infecções por fungos.
Para mais informações acompanhe o Blog Vida Saudável e siga a Pró-Saúde nas redes sociais!